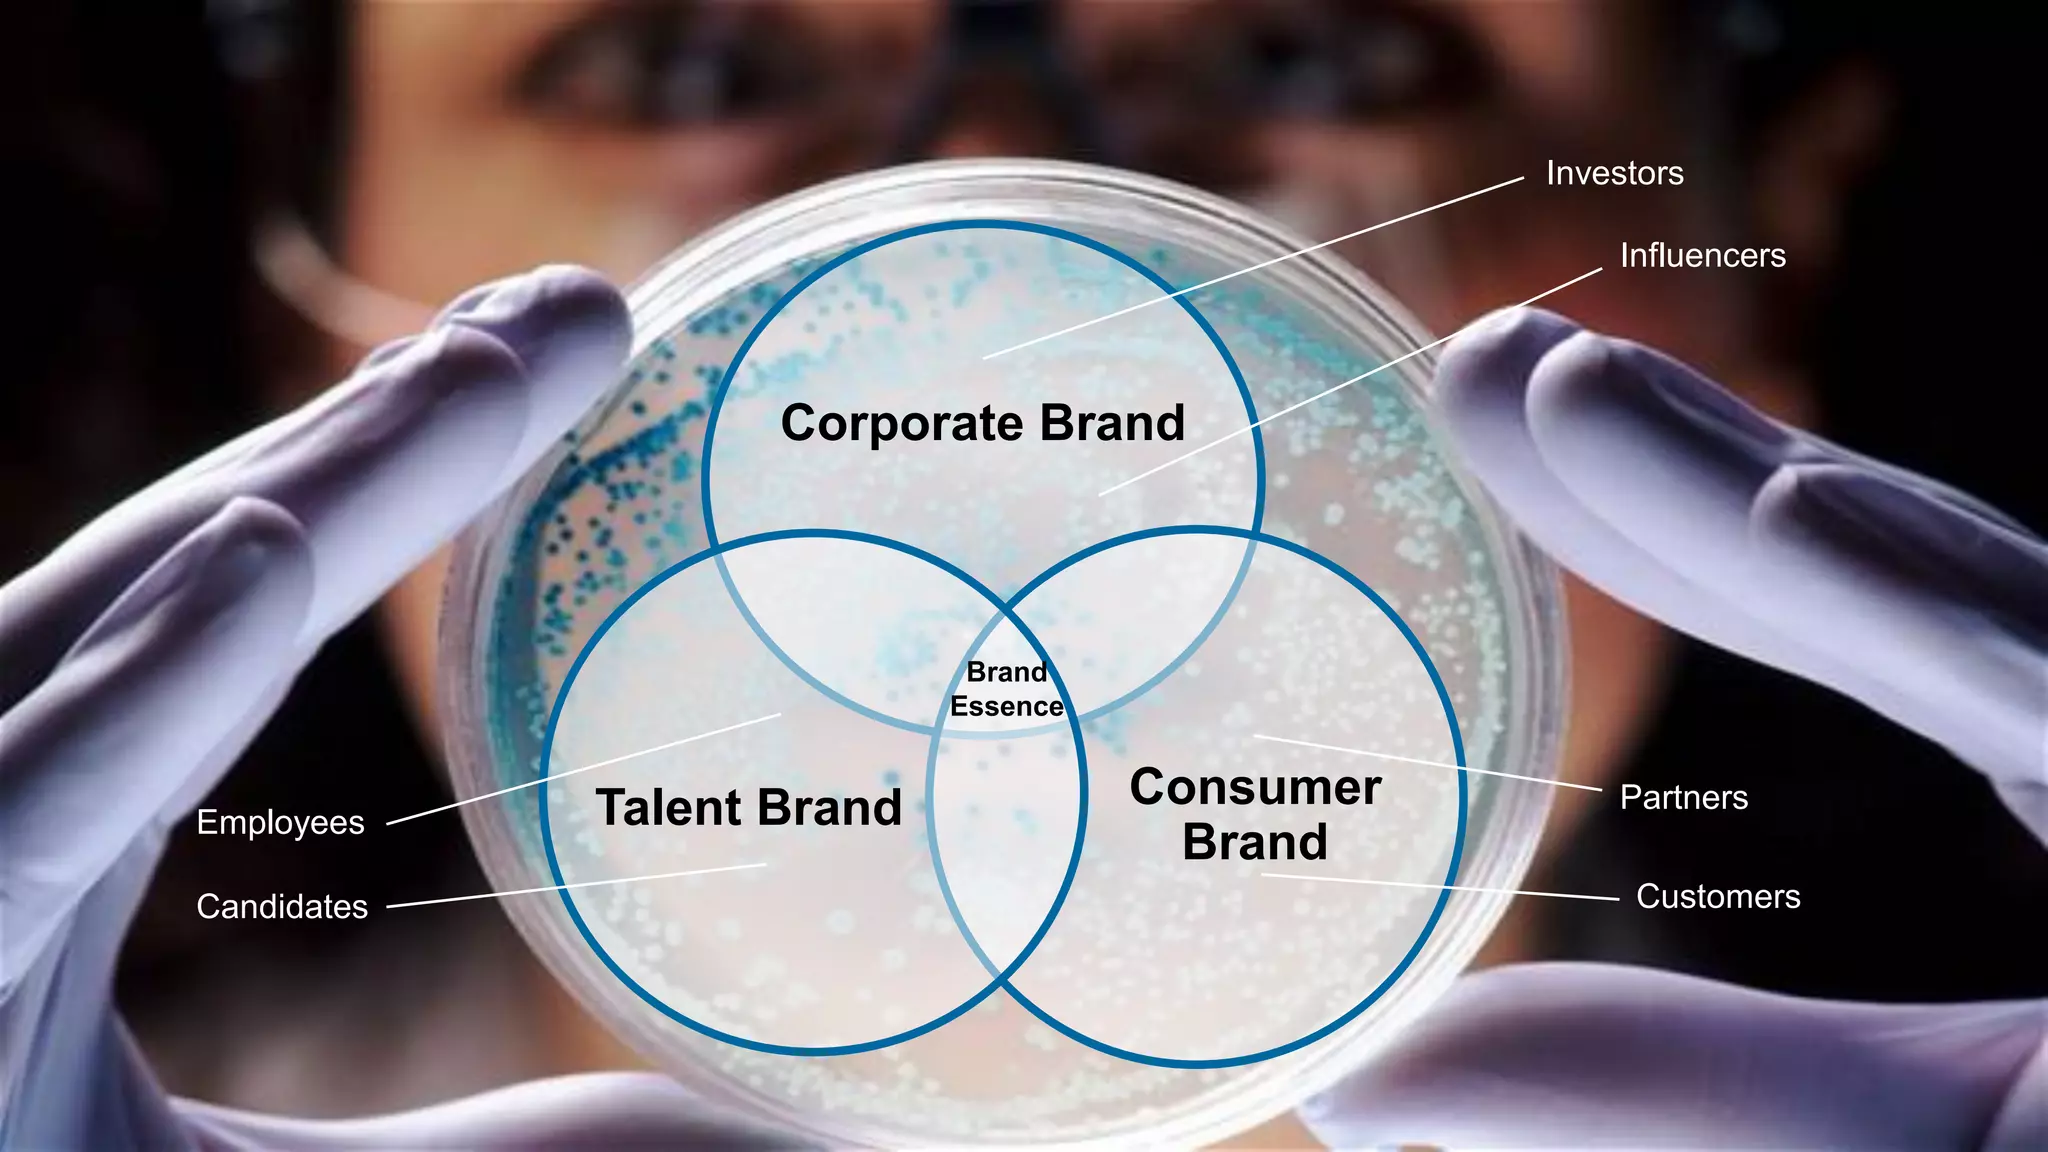
Corporate Brand
Consumer
Brand
Brand
Essence
Talent Brand
Investors
Influencers
Partners
Customers
Employees
Candidates

Embed presentation
Download to read offline






















The document discusses the importance of brand management in the digital environment, stressing that companies are overlooking significant communication channels and losing potential revenue. It emphasizes storytelling, employee advocacy, and an integrated approach to advertising across various platforms to enhance brand perception and influence consumer decisions. Key elements include recognizing that 70% of brand perception is shaped by experiences with people, thus leveraging employees as brand ambassadors is crucial.